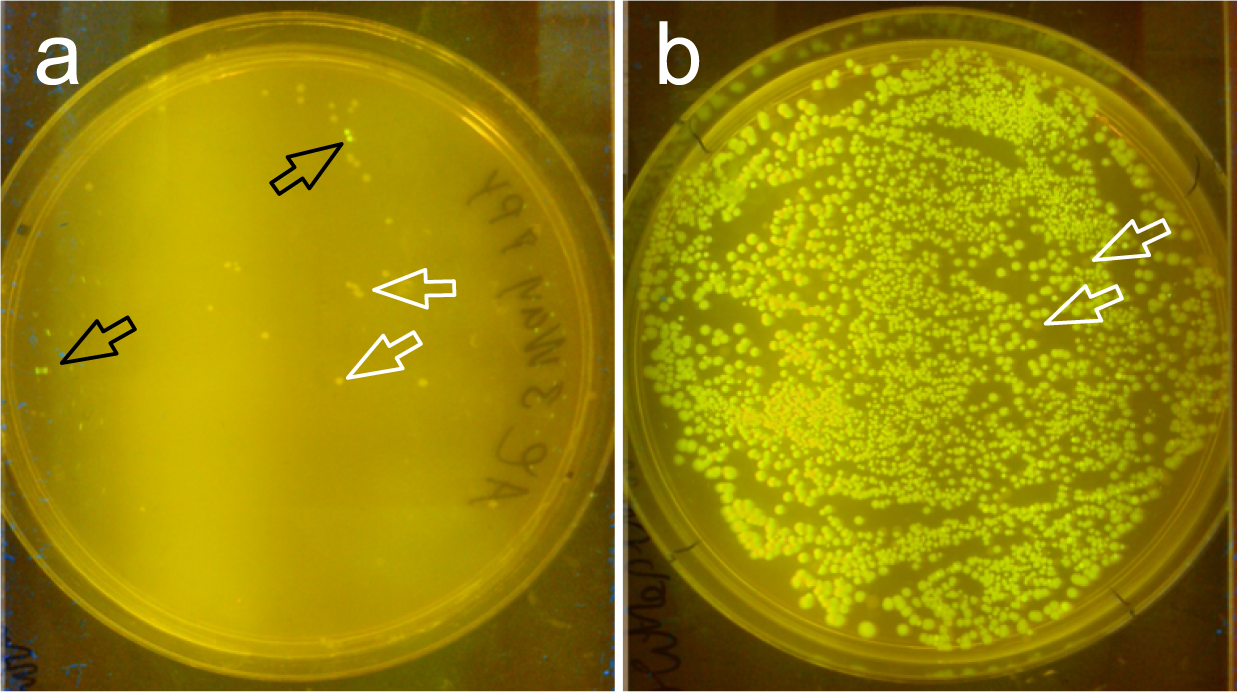
Figure 7

Figure 7
From: ZeBRα a universal, multi-fragment DNA-assembly-system with minimal hands-on time requirement
Arabinose induced chemically competent PPY-cells are not suitable for iVEC/“transformation-cloning”. (a) An example plate is shown with green fluorescent colonies resulting from iVEC/“transformation-cloning” with chemically competent, arabinose-induced PPY. We used pT7-HindIII-ccdB in the three-fragment assemblies as shown in Fig. 5, resulting in the GFP-expressing vector pT7-GFP antisense as readout. (b) Green fluorescent colonies resulting from ZeBRα-cloning using OTG extracts of autoinduced PPY. White arrows point at non-fluorescent colonies, black arrows in (a) point at GFP+ -colonies.